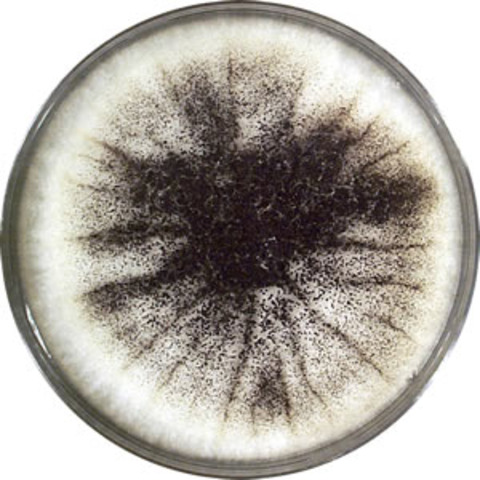
Modified Alpha Virus confirmed to cause sterility

-
Slums are vast in North and South American Regions. Police involvement is high to prevent riots. Unemployement rate is at nearly 50% for north americans.
-
The Alpha Virus Created by Peter Petrovic causes rapid cell division reducing the Hayflick limit of one's telomeres until cardiac arrest. The epidemic is uncontained. It begins in New York City.
-
Over the course of 3 years the alpha virus kills over 68% of the worlds population.
-
Peter Petrovic modifies the virus to change it's RNA structure. His attempts of an anti-viral solution were all failures. However, the modified Alpha Virus, exhibited no telomere shortening in lab tests.
-
The months since december showed that birth rates had become null.
-
After most of the world's central goverment was wiped out, and the virus no longer debilitating the populace, warlords begin to claim land via force.
-
After countless toddlers and children exhibit no change in growth in almost 2 years, doctors confirm that growth hormone is no longer apparent in any known human.
-
Speculation of the virus occurs when rumors of a 134 year old man surface.
-
Dr. Kandinsky announces to his academic audience that humanity is doomed to a fate of slow instinction.
-
Kandinsky launches the Genesis Project via the funding of an unnamed warlord/band. The Genesis Project began as an attempt to birth another human via artificial insemination with frozen sperm and eggs from 50 years in the past.
-
Dr. Kandinsky launches the Genisis Project
-
After 784,391 years of space travel the Genesis Project Lands on Gliese 581c.
A list shows items. A timeline shows sequence.
Use Timetoast to make dates, milestones, and turning points easier to understand in a clear visual format. Timetoast is a timeline maker for work, school, research, and stories.